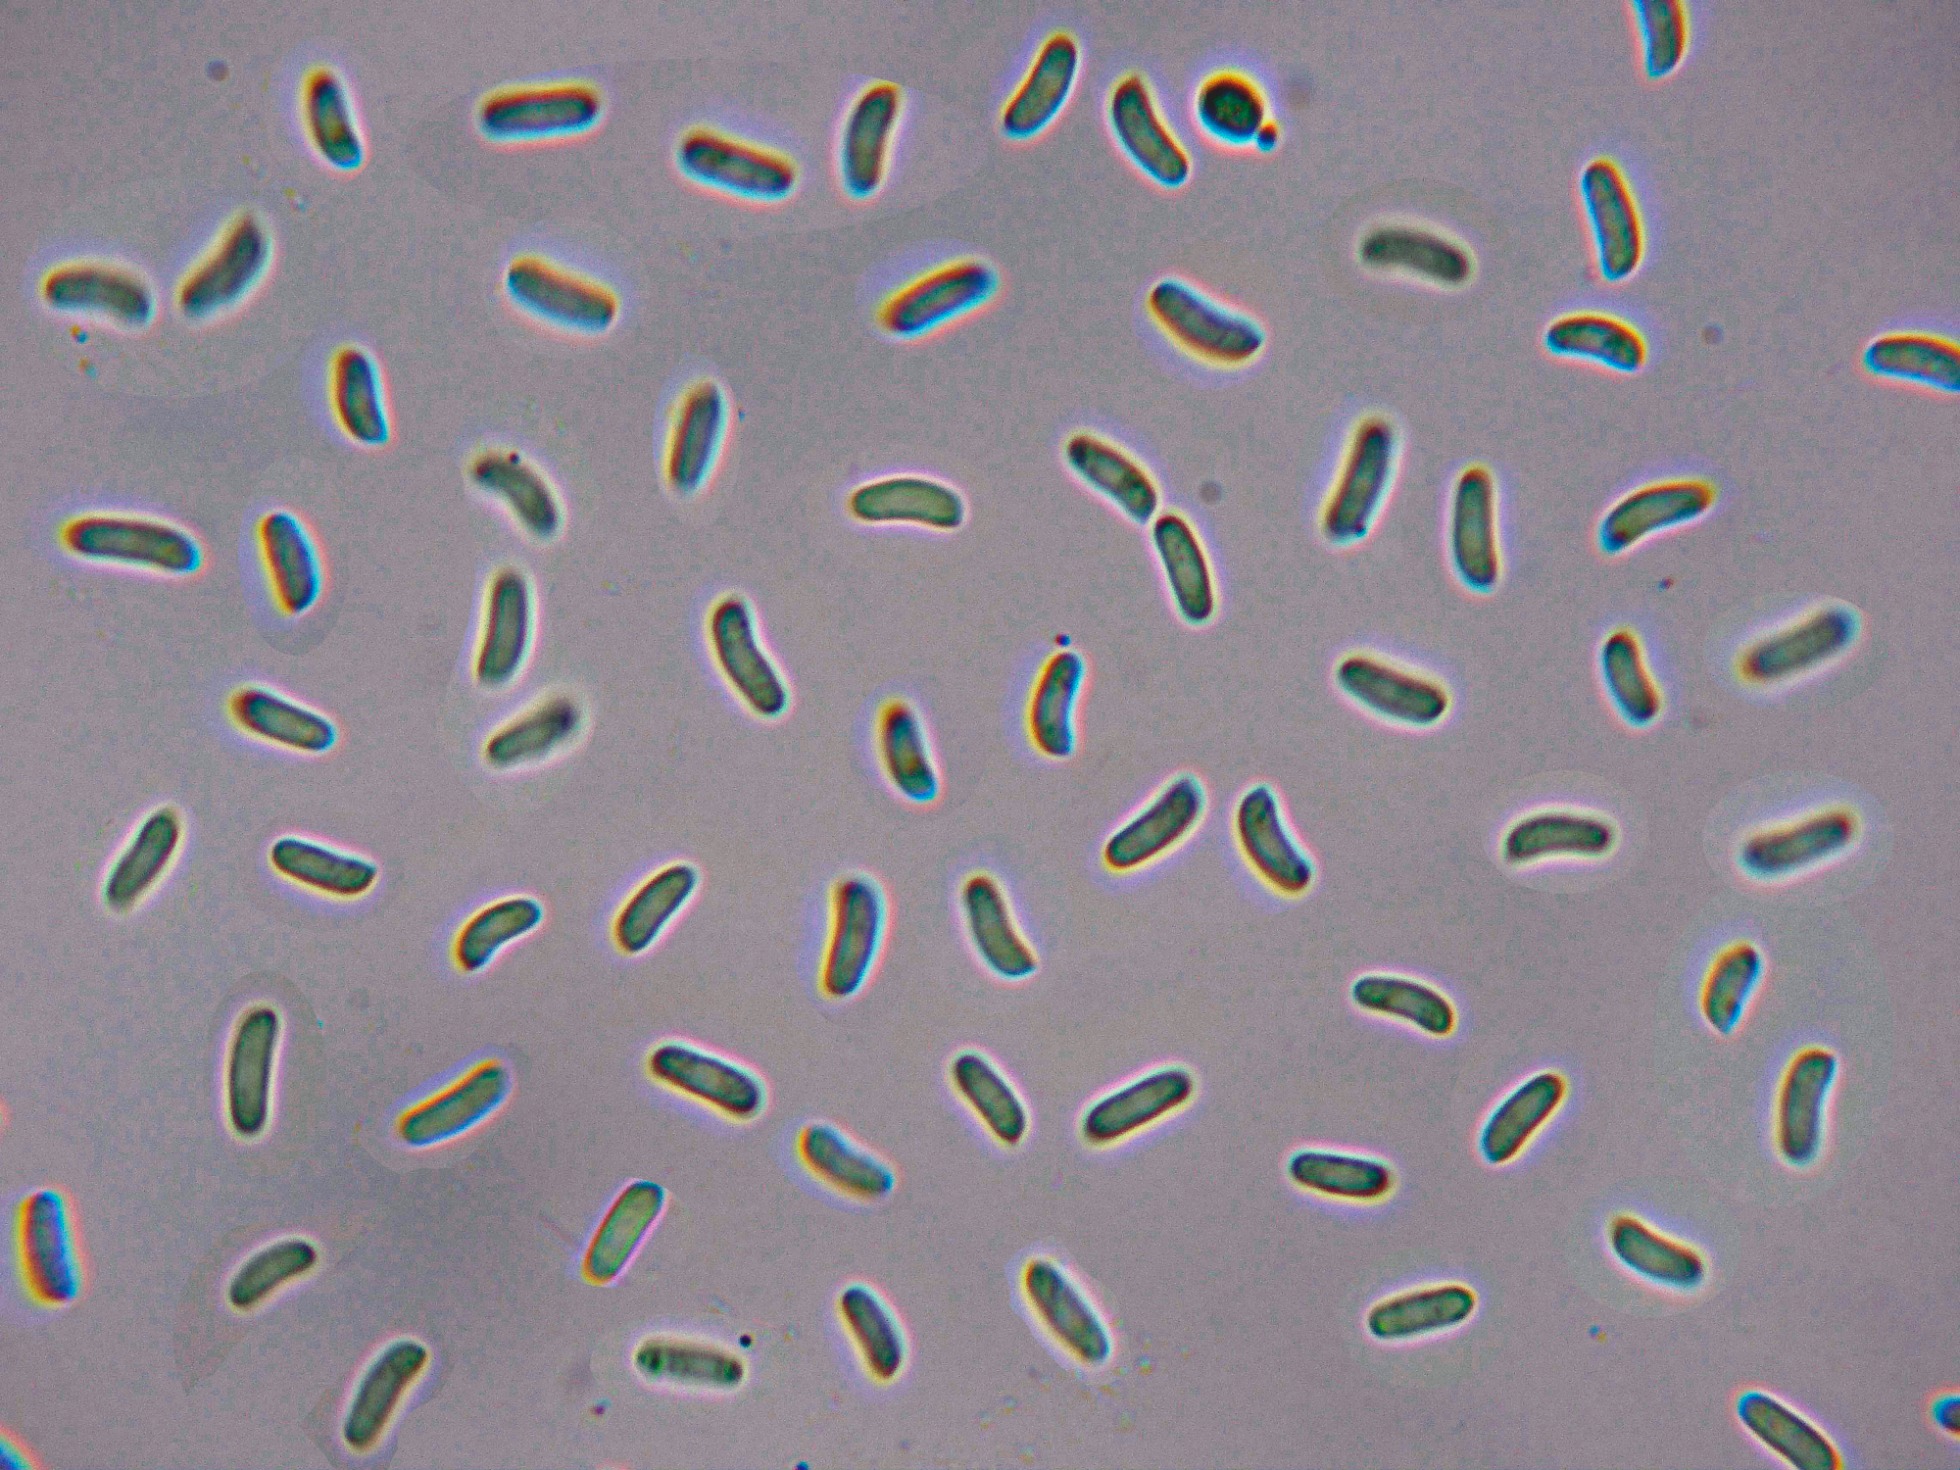

- Foro
- Foros sobre Micología de fungipedia
- Microscopía
- Una Peniophora que tenía pendiente: Peniophora rufa (Fr.) Boidin. Microscopía.
 Una Peniophora que tenía pendiente: Peniophora rufa (Fr.) Boidin. Microscopía.
Una Peniophora que tenía pendiente: Peniophora rufa (Fr.) Boidin. Microscopía.
- Josep Torres
-
 Autor del tema
Autor del tema
- Fuera de línea
- Moderador
-

Menos
Más
- Mensajes: 8746
- Gracias recibidas: 8379
2 años 11 meses antes #108845
por Josep Torres
Una Peniophora que tenía pendiente: Peniophora rufa (Fr.) Boidin. Microscopía. Publicado por Josep Torres
Hola a tod@s.
Una Peniophora de este pasado domingo, con un aspecto un tanto especial considerando el género, lo que abrevia mucho el camino a la hora de su correcta identificación.
Peniophora rufa (Fr.) Boidin
Sobre el tronco huésped compartiendo espacio con un liquen.
Unas ampliaciones a 20 aumentos.
Superficie del himenio con dispersos cistidios con cristales, que sobresalen por encima de los basidios.
Inmersos en el himenio unos cistidios de considerables dimensiones con contenido que se colorean fuertemente con la sulfovainillina.
Los cistidios con SV.
Los basidios de difícil observación.
Las esporas en agua:
Estas esporas obtenidas por esporulación natural y en agua con unas medidas de:
(6.6) 7 - 8.7 (9.4) × (2.2) 2.4 - 2.9 (3.1) µm
Q = (2.5) 2.7 - 3.2 (3.5) ; N = 32
Me = 7.8 × 2.7 µm ; Qe = 2.9
Saludos a tod@s.
Una Peniophora de este pasado domingo, con un aspecto un tanto especial considerando el género, lo que abrevia mucho el camino a la hora de su correcta identificación.
Peniophora rufa (Fr.) Boidin
Sobre el tronco huésped compartiendo espacio con un liquen.
Unas ampliaciones a 20 aumentos.
Superficie del himenio con dispersos cistidios con cristales, que sobresalen por encima de los basidios.
Inmersos en el himenio unos cistidios de considerables dimensiones con contenido que se colorean fuertemente con la sulfovainillina.
Los cistidios con SV.
Los basidios de difícil observación.
Las esporas en agua:
Estas esporas obtenidas por esporulación natural y en agua con unas medidas de:
(6.6) 7 - 8.7 (9.4) × (2.2) 2.4 - 2.9 (3.1) µm
Q = (2.5) 2.7 - 3.2 (3.5) ; N = 32
Me = 7.8 × 2.7 µm ; Qe = 2.9
Saludos a tod@s.
Adjuntos:
El siguiente usuario dijo gracias: Juan Andrés Román
Por favor, Identificarse para unirse a la conversación.
- Juan Andrés Román
-

- Fuera de línea
- Spammer
-

Menos
Más
- Mensajes: 2558
- Gracias recibidas: 2756
2 años 11 meses antes #108851
por Juan Andrés Román
Respuesta de Juan Andrés Román sobre el tema Una Peniophora que tenía pendiente: Peniophora rufa (Fr.) Boidin. Microscopía.
Buen aporte de esta vieja conocida.... Un abrazo Josep.
El siguiente usuario dijo gracias: Josep Torres
Por favor, Identificarse para unirse a la conversación.
- Josep Torres
-
 Autor del tema
Autor del tema
- Fuera de línea
- Moderador
-

Menos
Más
- Mensajes: 8746
- Gracias recibidas: 8379
2 años 10 meses antes #108855
por Josep Torres
Respuesta de Josep Torres sobre el tema Una Peniophora que tenía pendiente: Peniophora rufa (Fr.) Boidin. Microscopía.
Por favor, Identificarse para unirse a la conversación.
- Foro
- Foros sobre Micología de fungipedia
- Microscopía
- Una Peniophora que tenía pendiente: Peniophora rufa (Fr.) Boidin. Microscopía.
Tiempo de carga de la página: 0.214 segundos

Foro de micología